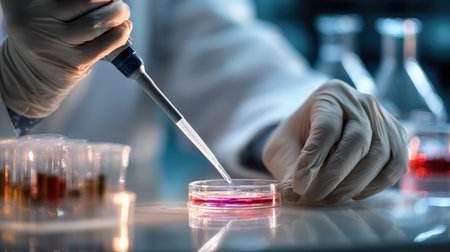
A laboratory technician carefully uses a pipette to transfer vibrant liquid into a petri dish, demonstrating precision in a modern research environment focused on scientific study.の素材

素材 - A laboratory technician carefully uses a pipette to transfer vibrant liquid into a petri dish, demonstrating precision in a modern research environment focused on scientific study.
作品情報
A laboratory technician carefully uses a pipette to transfer vibrant liquid into a petri dish, demonstrating precision in a modern research environment focused on scientific study.
- ID:259607835
- 作品種別:
- 作者名:Phattarasaya Glubpis
キーワード
- accuracy
- analysis
- analysis procedure
- biological sample
- biology
- bright colors
- careful
- chemicals
- cleanliness
- detailed work
- diagnostics
- equipment
- examination
- experiment
- fluid transfer
- focused work
- glassware
- gloves
- healthcare
- innovation
- lab technician
- laboratory
- laboratory equipment
- laboratory setting
- life sciences
- liquid
- measurement
- microbiology
- modern laboratory
- observation
- petri dish
- petri dish experiment
- pipette
- pipetting
- precision
- professional
- research
- research facility
- safety
- science
- science equipment
- scientific method
- specimen
- sterile
- study
- technician
- test
- testing
- workplace
類似作品
Blurred of red ...
Modern scientis...
professional ch...
Researcher usin...
Collaboration, ...
Young woman sci...
Scientist with ...
Collaboration, ...
Professional sc...
Wearing white c...
Laboratory assi...
Pink and blue. ...
lab, team of me...
Acid-base react...
Senior woman, s...
scientist worki...
scientist worki...
The master in m...
professional ch...
Blood test in t...
Scientist in me...
Scientist pipet...
Busy technician...
Group of dedica...
Scientist in la...
Researchers wor...
A woman in lab ...
Young scientist...
a medic in a pr...
Pipette in hand...
Coronavirus cov...
Scientist using...
Skillful two sc...
Laboratory test...
Young Scientist...
Blood test. Pro...
Group of chemis...
Bioarcheology. ...
A dedicated sci...
close up of han...
Collaboration, ...
Laboratory work...
scientist worki...
beauty scientis...
Scientists extr...
Collaboration, ...
medical marijua...
A female techni...
A scientist is ...